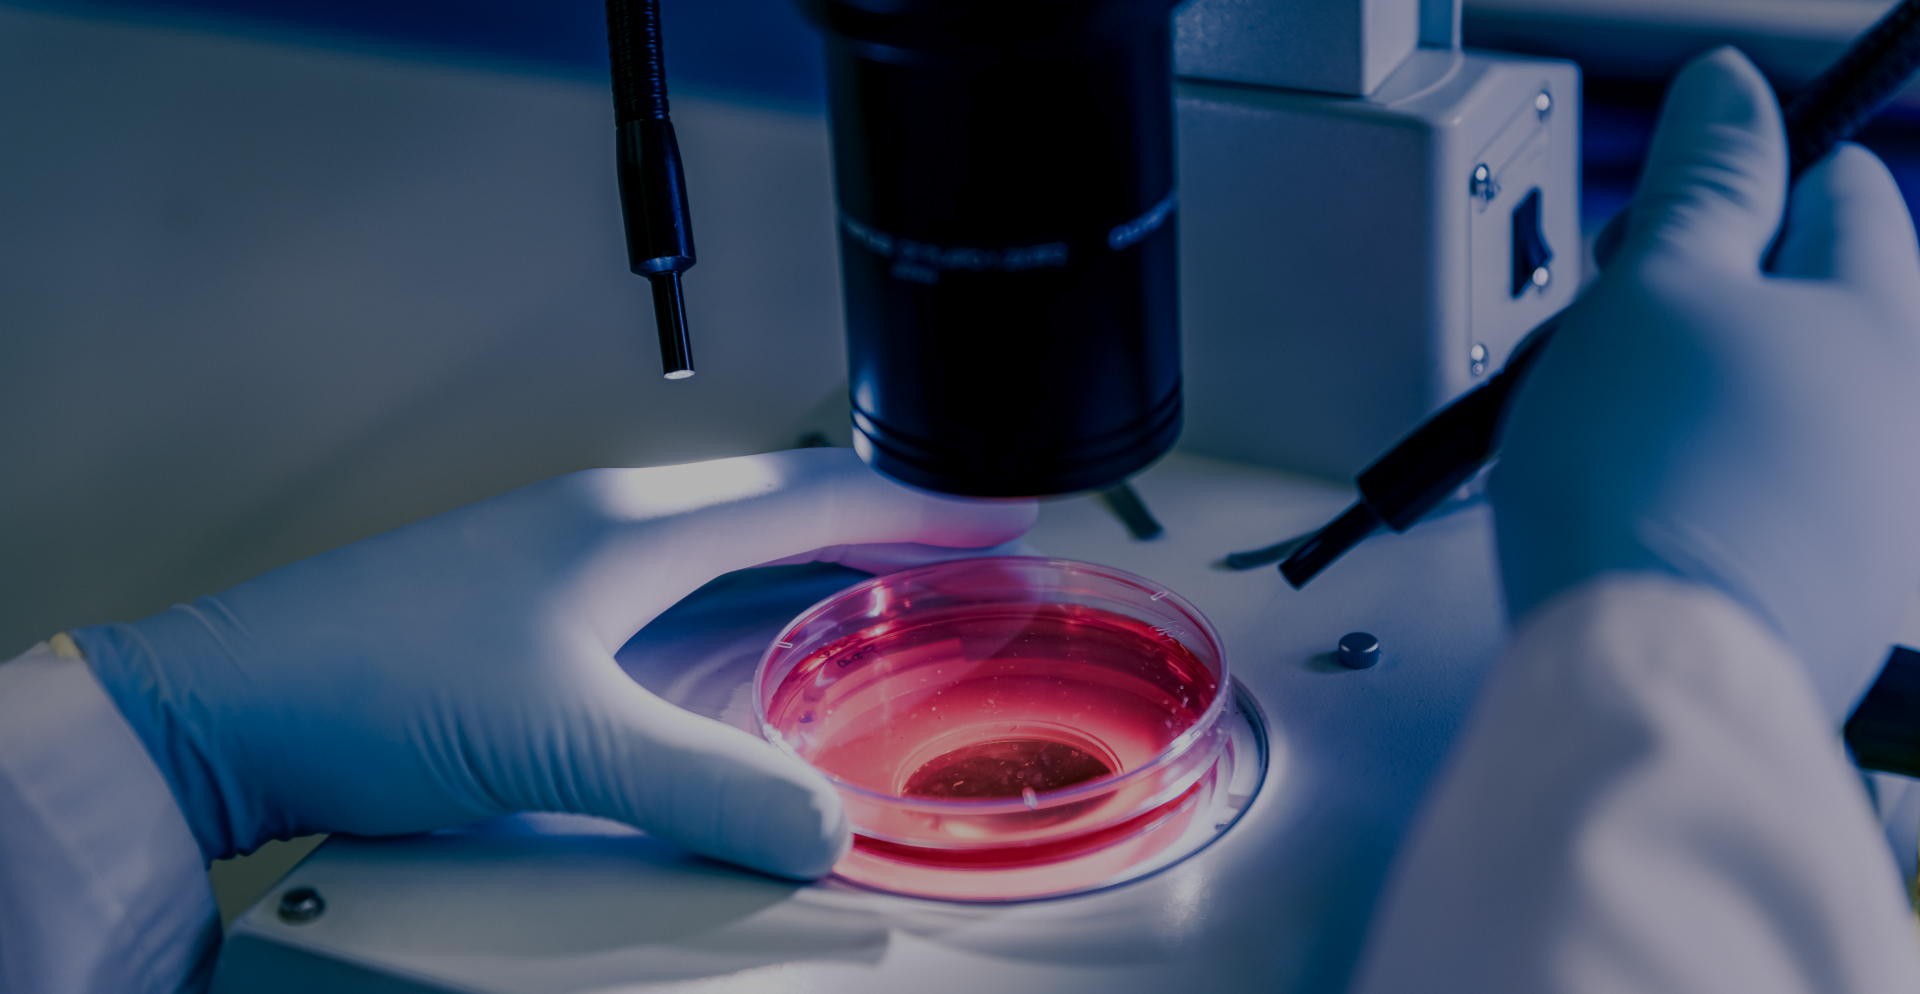

Handle presente no Congresso Internacional de Medicina Obstétrica do Grupo Santa Joana
Nos dias 08 e 09 de novembro, acontecerá o Congresso Internacional de Medicina Obstét...

INOVAÇÃO E ALTO DESEMPENHO
Soluções para clínicas e laboratórios de reprodução assistida, desenvolvidos para sustentar resultados consistentes.
Somos representantes exclusivos da linha Kitazato no Brasil. Com mais de 25 anos dedicados à pesquisa, ao desenvolvimento e à fabricação de dispositivos médicos, seu amplo portfólio abrange uma extensa gama de tratamentos de fertilidade, com destaque para o desenvolvimento do Método Cryotop®, que transformou definitivamente a rotina dos laboratórios de FIV e trouxe enorme contribuição para o campo da reprodução assistida.

Atuamos de forma integrada à operação das clínicas, oferecendo não apenas produtos, mas serviços estruturados, suporte técnico e modelos logísticos eficientes.
Nossa estrutura é preparada para sustentar, com exclusividade no mercado brasileiro, os padrões de qualidade e suporte da Kitazato, o que garante acompanhamento de estoque personalizado, com disponibilidade contínua e previsibilidade operacional.

Estamos presentes em todo o território nacional, com força de vendas própria.
Explore as principais notícias, artigos e vídeos sobre a Endorse e o mercado onde atuamos.

Nos dias 08 e 09 de novembro, acontecerá o Congresso Internacional de Medicina Obstét...

Nos últimos anos, muitos avanços técnicos e tecnológicos vêm surgindo e revolucionand...

O SIAPARTO – Simpósio Internacional de Assistência ao Parto, acontecerá entre 0...